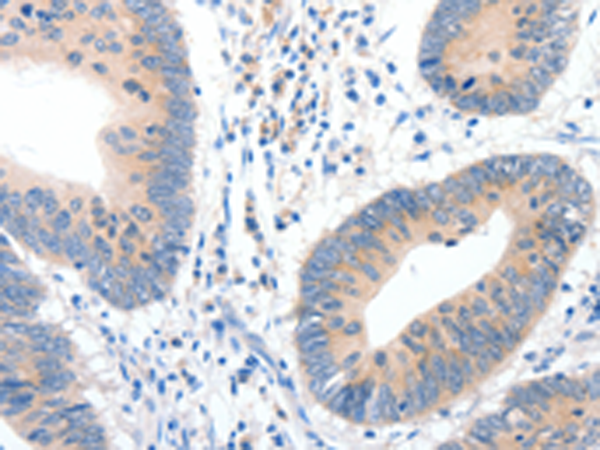
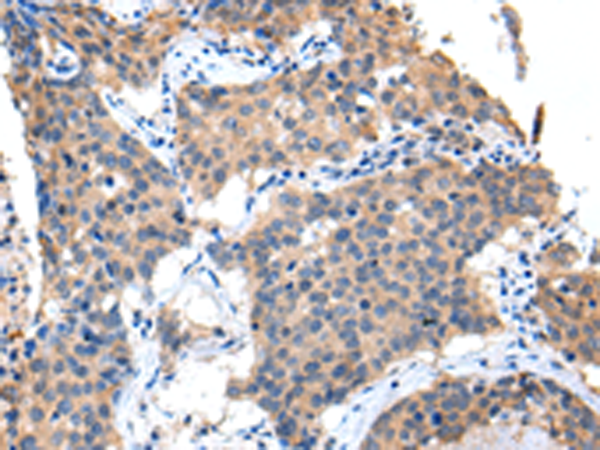

-
分类: 科研抗体货号: P10897别名: RVP1, HRVP1, C7orf1, CPE-R2, CPETR3应用: IHC反应种属: Human
-
分类: 科研抗体货号: P10915别名: GLP1, GLP2, GRPP应用: IHC反应种属: Human, Mouse, Rat
-
分类: 科研抗体货号: P10908别名: GK, GLK, HK4, HHF3, HKIV, HXKP, LGLK, MODY2, FGQTL3应用: IHC反应种属: Human, Mouse, Rat
-
分类: 科研抗体货号: P10896别名: Z38; C3orf4; GENX-3745应用: WB,IHC反应种属: Human, Mouse
-
分类: 科研抗体货号: P10914别名: GHDP应用: WB反应种属: Human, Mouse, Rat
-
分类: 科研抗体货号: P10907别名: PBP; TC1; TC2; TGB; LDGF; MDGF; TGB1; B-TG1; CTAP3; CXCL7; NAP-2; SCYB7; THBGB; LA-PF4; THBGB1; Beta-TG; CTAPIII; CTAP-III应用: WB,IHC反应种属: Human
-
分类: 科研抗体货号: P10927别名:应用: WB,IHC反应种属: Human, Mouse, Rat
-
分类: 科研抗体货号: P10913别名: GHBP; GHIP应用: WB反应种属: Human, Mouse, Rat
-
分类: 科研抗体货号: P10906别名: AXSF, AXLLG应用: IHC反应种属: Human
-
分类: 科研抗体货号: P10926别名: HH3; KAL3; PKR2; GPRg2; GPR73b; GPR73L1; dJ680N4.3应用: WB,IHC反应种属: Human, Mouse

鄂公网安备42018502007531号
鄂公网安备42018502007531号

